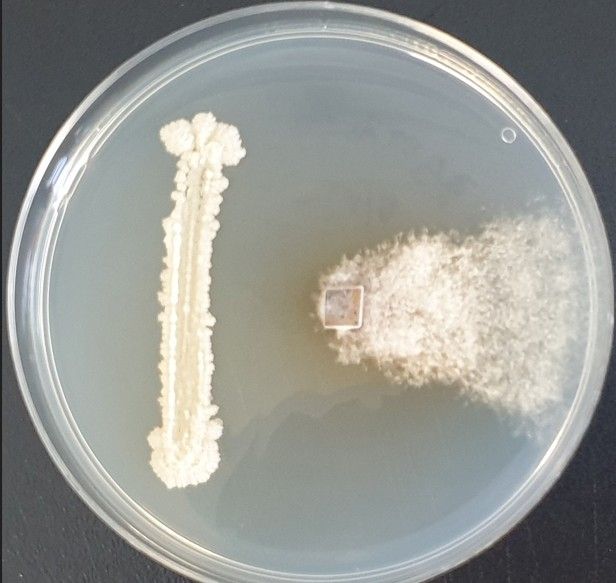
내생균 항균 활성 시험

(해남=연합뉴스) 조근영 기자 = 전남 해남군이 고구마 재배 시 최대 악성 병해로 꼽히는 덩이줄기썩음병을 잡는 미생물을 개발, 실증시험에 착수했다고 17일 밝혔다.
개발한 미생물은 식물 내부에 공생하는 미생물인 내생균(endophyte)으로, 고구마에서 분리했다.
이 미생물 개발은 세계 최초로 명품 해남고구마의 위상을 다시 한번 확인할 수 있는 계기가 되고 있다고 군은 설명했다.
'바실러스 HN01'로 명명된 미생물은 고구마 조직 내에 자연스럽게 정착해 병원균의 침투를 차단하거나 성장을 억제하는 생물학적 방어체계를 형성한다.
고구마 내부와 외부 모두에서 작용하는 일종의 '생물학적 보디가드'로 외부 병원균의 침입을 막고, 고구마의 면역 체계를 강화해 주게 된다.
내생균 활용은 화학 농약 사용에 비해 친환경적이어서 지속 가능한 방제 기술로도 주목하고 있다.
덩이줄기썩음병은 고구마 뿌리나 줄기에 침투해 부패를 유발하는 병해다.
육묘기와 생육기뿐 아니라 저장 기간 중에도 발생할 수 있어 수확 이후에도 손실을 초래하는 주요 병해로 알려졌다.
이번 실증 시험에서는 고구마 육묘상과 노지 재배지에서 내생균 처리에 따른 고구마 생육 안정성과 병 예방 효과를 확인하는 한편 고구마 생산성에 미치는 영향을 평가할 예정이다.
실증 시험 결과에 따라 해당 내생균의 특허 출원을 진행하고, 고구마 재배 농가 공급도 단계적으로 추진할 계획이다.
군 관계자는 "고구마 농가의 최대 골칫거리인 고구마줄기썩음병 저감의 새로운 해결책으로 내생균에 주목해 연구를 진행한 결과 큰 성과를 거두게 됐다"고 말했다.
chogy@yna.co.kr
Copyright ⓒ 연합뉴스 무단 전재 및 재배포 금지
본 콘텐츠는 뉴스픽 파트너스에서 공유된 콘텐츠입니다.